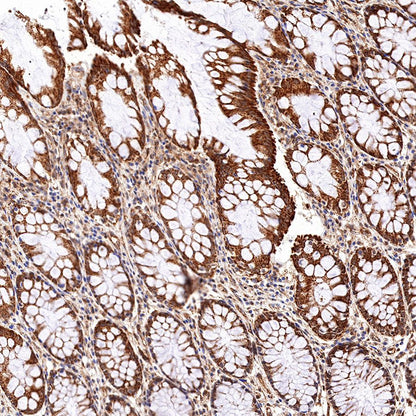
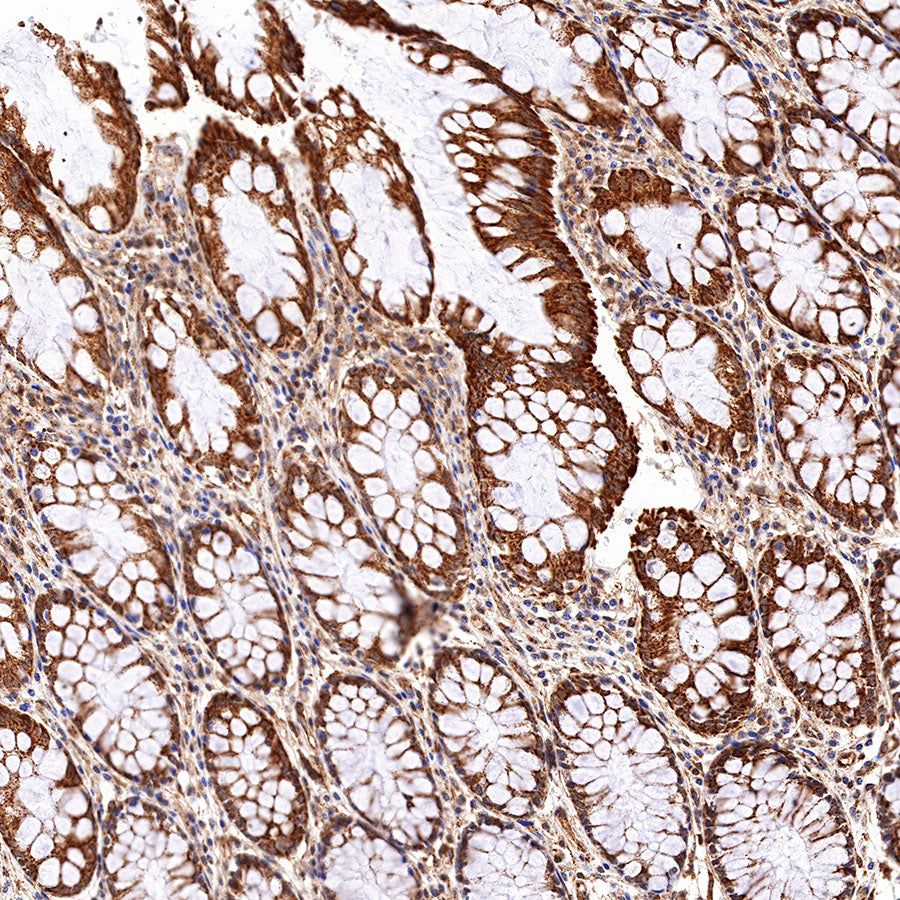
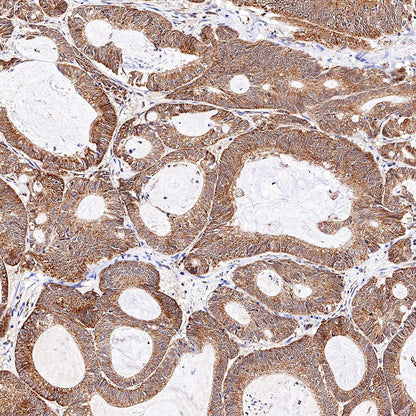

Product Details
Product Details
Product Specification
| Host | Rabbit |
| Antigen | Stat6 |
| Synonyms | IL-4 Stat, Signal transducer and activator of transcription 6 |
| Immunogen | Synthetic Peptide |
| Location | Cytoplasm, Nucleus |
| Accession | P42226 |
| Clone Number | SDT-337-32 |
| Antibody Type | Recombinant mAb |
| Application | WB, IHC-P, ICC, IP, ICFCM |
| Reactivity | Hu, Ms |
| Purification | Protein A |
| Concentration | 0.5 mg/ml |
| Physical Appearance | Liquid |
| Storage Buffer | PBS, 40% Glycerol, 0.05% BSA, 0.03% Proclin 300 |
| Stability & Storage | 12 months from date of receipt / reconstitution, -20 °C as supplied |
Dilution
| application | dilution | species |
| WB | 1:1000 | |
| IHC-P | 1:500 | |
| ICC | 1:250 | |
| ICFCM | 1:500 | |
| IP | 1:50 |
Background
Signal Transducer and Activator of Transcription 6 (STAT6), belonging to a family of seven similar members is primarily stimulated by interleukin(IL)-4 and IL-13, and acts as a T helper type 2 (Th2)-inducing factor. Thus, it is implicated in the pathophysiology of various allergic conditions, such as asthma, atopic dermatitis, eosinophilic esophagitis and food allergies, but also in tumor microenvironment regulation. Furthermore, certain forms of lymphomas, notably the Hodgkin lymphoma group, the primary mediastinal and primary central nervous system lymphoma, as well as some follicular and T cell lymphomas are associated with dysregulation of the STAT6 pathway [PMID: 33991851].
Picture
Picture
Western Blot

FC

IP
Stat6 Rabbit mAb at 1/50 dilution (1µg) immunoprecipitating Stat6 in 0.4mg HeLa whole cell lysate.
Western blot was performed on the immunoprecipitate using Stat6 Rabbit mAb at 1/1000 dilution.
Secondary antibody (HRP) for IP was used at 1/400 dilution.
Lane 1 : HeLa whole cell lysate 20µg(input)
Lane 2 : Stat6 Rabbit mAb IP in HeLa whole cell lysate
Lane 3 : Rabbit monoclonal IgG IP in HeLa whole cell lysate
Predicted MW: 94 kDa
Observed MW: 110 kDa
Immunohistochemistry





Immunocytochemistry